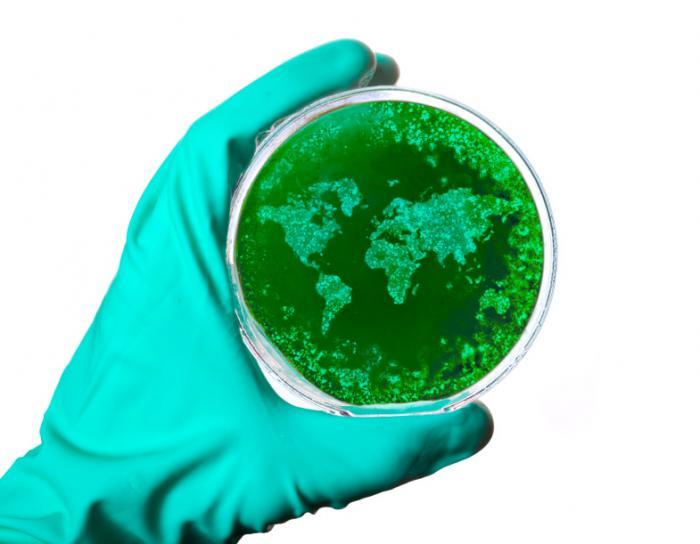

God’s Promise – I am the Truth
The ugly truth is being exposed every day, and the quick response from corporate owners is, we were there for you until we weren’t, we’ve made mistakes, and the consequence is that you no longer trust us. We want to earn your trust back.
Can we earn truth, or is it something given with the hope that it will be fulfilled? Our society is caught in a truth debacle. This is not a new phenomenon. The difference now is that we are in a principality war that has been waged in cyberspace. The definitive nature of truth has become nothing more than exposing of what is deemed right and expedient to meet carnal (worldly) needs.
The arrival of the twenty-first century ushered us into a technology-based reality. The onset of fake news exposes the question of ‘truth.’ Is truth determined by the conveyor or the recipient of what has been shared? There are so many factors in determining the truth. But these factors only affect this plane, Satan’s home. Absolute truth is only available to followers of Christ. Those of us that have received Christ as our Lord and Savior, know that truth is revealed throughout the Bible. Truth is the same yesterday, today and tomorrow. It begins with God who is the Word, and the Word which is (all) truth.
The Word (Christ) was in the beginning. The Word was with God. The Word was God. John 1:1 NLV
My followers do not belong to the world just as I do not belong to the world. 17 Make them holy for Yourself by the truth. Your Word is truth. 18 “As You sent Me into the world, so I have sent them into the world also. 19 I set Myself apart to be holy for them. Then they may be made holy by the truth. John 17:16-19 NLV
Of His own will He brought us forth by the word of truth, that we might be a kind of firstfruits of His creatures. James 1:18 NKJV
He chose to give us birth through the Word of truth that we might be a kind of firstfruits of all he created. James 1:18 ESV
God is the Word, the Word is truth, and he created us to share the truth. Why you may ask? God created us to replicate Him on earth and to share the truth. The Armor of God speaks to wearing the belt of truth as part of our daily armor to protect ourselves from false truth known today as fake news, to expose the fake truth and to share the Word which is (all) truth, also known as the ‘Good News.’
Stand therefore, having your loins girt about with truth. Ephesians 6:14 KJV
Stand then, with the belt of truth buckled around your waist. Ephesians 6:14 ESV
Earlier posts focused on the fact that as Christians we cannot be careless about who we are. We cannot allow carnal truths affect what we know to be the real truth, and we cannot become fearful of chaos created by fake news. We are to stand fast, not waver, and rest in the Word.
We have been commanded to reflect the qualities of Christ, to choose to emulate Him, allow his righteousness to flow through us and share the truth by exposing the (fake) carnal truth. We must share that God is the truth.
Jesus saith unto him, I am the way, the truth, and the life; no man cometh unto the Father, but by me. John 14:6
Chaos is of Satan, the truth is of God. Our salvation is through the acceptance of Christ which not only sets us free but sets us apart from the carnal lies and deceit  of man.
of man.
Bear in mind that our Lord’s patience means salvation, just as our dear brother Paul also wrote you with the wisdom that God gave him. He writes the same way in all his letters, speaking in them of these matters. His letters contain some things that are hard to understand, which ignorant and unstable people distort, as they do the other Scriptures, to their own destruction. Therefore, dear friends, since you have been forewarned, be on your guard so that you may not be carried away by the error of the lawless and fall from your secure position. But grow in the grace and knowledge of our Lord and Savior Jesus Christ. To him be glory both now and forever! Amen. 2 Peter 3:15-18
And consider that the longsuffering of our Lord is salvation—as also our beloved brother Paul, according to the wisdom given to him, has written to you, as also in all his epistles, speaking in them of these things, in which are some things hard to understand, which untaught and unstable people twist to their own destruction, as they also do the rest of the Scriptures. You, therefore, beloved, since you know this beforehand, beware lest you also fall from your own steadfastness, being led away with the error of the wicked; but grow in the grace and knowledge of our Lord and Savior Jesus Christ. To Him be the glory both now and forever. Amen.2 Peter 3:15-18 NKJV
Apologies are not a form of repentance. The world apologizes, makes visual changes and continues down its path of deception. Christians understand God’s truth and repent for committing sin. Christians seek redemption and renewal.
Do not be trapped in the lies perpetrated by the world. Do not be led away with  the error of the wicked. Know our Lord is truth, and whether we suffer the world’s attacks here on earth, we are living our lives to hear our Lord say, “Well done, good and faithful servant! Come and share your master’s happiness.” Matthew 25: 23
the error of the wicked. Know our Lord is truth, and whether we suffer the world’s attacks here on earth, we are living our lives to hear our Lord say, “Well done, good and faithful servant! Come and share your master’s happiness.” Matthew 25: 23

Images – Free Google Images
Scriptures – BibleGateway.com
Thank you for spending time on my sites, if you like what you are reading, follow me, lisasdailyinspirations.wordpress.com and receive the daily inspirations in your inbox, or visit my other site, youngchristianwarriors.com and subscribe.

of man.
of man. the error of the wicked. Know our Lord is truth, and whether we suffer the world’s attacks here on earth, we are living our lives to hear our Lord say, “Well done, good and faithful servant! Come and share your master’s happiness.” Matthew 25: 23
the error of the wicked. Know our Lord is truth, and whether we suffer the world’s attacks here on earth, we are living our lives to hear our Lord say, “Well done, good and faithful servant! Come and share your master’s happiness.” Matthew 25: 23




